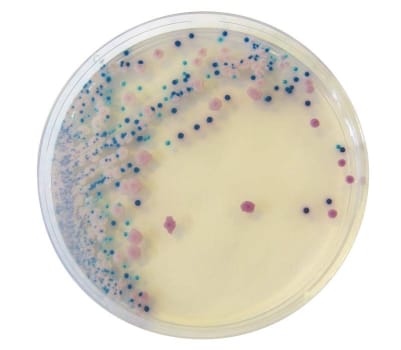
Oxoid, Chromagarplader, Brilliance UTI Clarity, 9 cm

Oxoid, Chromagarplader, Brilliance UTI Clarity, 9 cm
Varenr. 50038411 (Tidligere varenr. 6435999)
Størrelse: 9 cm
Salgsenhed: æske a 10 stk
På lager
Produktbeskrivelse
Køb Brilliance UTI Clarity kromogent medium online hos Mediq. Brilliance UTI Clarity kromogent medium er et effektivt diagnostisk værktøj til hurtig og præcis identifikation af urinvejspatogener i kliniske prøver. Det muliggør identifikation uden behov for yderligere bekræftelse af E. coli.
Værd at vide om Brilliance UTI Clarity:
- Kromogent medium til isolering og identifikation af urinvejspatogener
- Differentierer op til syv farver af kolonivækst
- Kræver ingen yderligere E. coli-bekræftelse
- Resultater på kun 18–24 timer
- Gennemsigtig baggrund for tydelig visuel tolkning
- Detekterer enzymaktiviteter som β-galactosidase og β-glucosidase
Mere information:
Brilliance UTI Clarity kromogent medium er udviklet til klinisk mikrobiologi og gør det muligt hurtigt at identificere de mest almindelige bakterier ved urinvejsinfektioner. Ved hjælp af specifikke enzymreaktioner og farveindikatorer adskiller det forskellige bakteriearter baseret på kolonifarve. E. coli og S. saprophyticus danner pink/røde kolonier, enterokokker giver blå/turkise kolonier, og coliforme bakterier identificeres ved mørkeblå/lilla vækst. Proteus-, Morganella- og Providencia-arter skelnes med brun ring. Det sparer laboratorier tid og øger diagnostisk nøjagtighed.
Sådan anvender du Brilliance UTI Clarity kromogent medium:
Påfør prøvematerialet direkte på mediet og inkuber pladerne ved passende temperatur i 18–24 timer. Kolonier vurderes visuelt ud fra farve og morfologi. Gennemsigtig baggrund fremhæver farveforskelle, hvilket letter identifikation. Der er ikke behov for supplerende tests ved påvisning af E. coli, hvilket effektiviserer arbejdsgangen i laboratoriet. Mediets formulering understøtter tydelig vækst og pålidelig tolkning.
Information til sundhedsfaglige personer
Brilliance UTI Clarity anvender kromogene substrater, som spaltes af specifikke bakterieenzymer. β-galactosidase og β-glucosidase identificerer hhv. E. coli/S. saprophyticus og enterokokker. Kombination af begge giver coliforme bakterier en karakteristisk farve. Tryptofan-deaminase-aktivitet markeres ved brun zone omkring visse Proteus-gruppe-organismer. Mediet reducerer behovet for bekræftende test og understøtter standardiseret mikrobiologisk praksis.
Kliniske forhold og anvendelse:
- Anvendes til urinvejsinfektionsscreening
- Identificerer E. coli uden yderligere test
- Skelner hurtigt mellem patogene bakterier
- Egnet til rutinediagnostik i kliniske laboratorier
- Tolkning via farvekode forenkler arbejdsgange
Specifikationer
- Varenr.
50038411
- Salgsenhed
æske a 10 stk
- Brand
Oxoid
- Leverandørvarenr.
PO5159A
- Dybde
19 cm
- Bredde
7 cm
- Højde
9 cm
- Bruttovægt
.308 kg
- Nettovægt
.34 kg
- Bruttovolumen
1.197 dm3
- Nettovolumen
0 dm3
- Størrelse
9 cm
- Er steril
Nej
Dokumenter